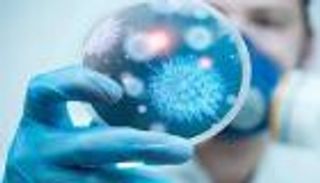
رصد حالة إصابة بفيروس كورونا شمال إنجلترا

التهابات فيروس كورونا أكثر فتكا بمصابي السكري

الباحثون يكتشفون أن الفئران المصابة بالسكري أظهرت استجابة طويلة الأمد بالرئة، مقارنة مع استجابة قصيرة لدى الفئران غير المصابة
منذ ظهور فيروس كورونا عام 2012، كان هناك أكثر من 2400 حالة مؤكدة من حالات العدوى، مما أدى إلى وفاة أكثر من 800 شخص، بمعدل وفيات مزعج يبلغ 35%، ولهذا السبب كان الباحثون حريصين على تحديد أي عوامل خطر تسهم في تطور مرض شديد أو فتاك.
وتشير الدلائل السريرية الحالية التي تضمنتها دراسة نشرت في العدد الأخير من دورية رؤى التحقيقات السريرية "JCI Insight" إلى أن مرض السكري، هو أحد عوامل الخطر الرئيسية بالإضافة إلى الأمراض المصاحبة الأخرى بما في ذلك أمراض الكلى وأمراض القلب وأمراض الرئة.
وخلال الدراسة التي أجراها باحثون من كلية الطب بجامعتي ماريلاند وجونز هوبكنز الأمريكيتين على فئران التجارب، وجد الباحثون أن الفئران المصابة بالسكري أظهرت استجابة التهابية متأخرة وطويلة الأمد في الرئة عند الإصابة بفيروس كورونا، مقارنة مع استجابة التهابية قصيرة عند الفئران غير المصابة بالمرض.
وأعزت الدراسة ذلك إلى أن لدى الفئران المصابة بمرض السكري مستويات أقل من السيتوكينات الالتهابية، وعددا أقل من الخلايا الضامة الالتهابية والخلايا التائية، وهذا يشير إلى أن زيادة شدة الإصابة بفيروس كورونا في مرضى السكري قد يكون سببه خللا في استجابة الجسم المناعية للعدوى.
ويقول ماثيو فريمان، أستاذ مشارك في علم الأحياء المجهرية وعلم المناعة ومؤلف الدراسة، في تقرير نشره موقع جامعة ماريلاند 19 أكتوبر/تشرين الأول الجاري: "فهم طريقة مساهمة السكري في شدة المرض بعد الإصابة بفيروس كورونا أمر بالغ الأهمية، وخطوتنا التالية تحديد ما الذي يدفع الاستجابة المناعية المتغيرة لدى مرضى السكري وكيفية عكس تلك الآثار مع العلاجات لعلاج المرضى".
ويضيف: "يمكن أن تستكشف أبحاث المتابعة أيضًا ما إذا كان ينبغي لمقدمي الرعاية الصحية مضاعفة جهودهم لإدارة وتثبيت مستويات الجلوكوز في مرضى السكري الذين يعانون من عدوى تنفسية خطيرة وما إذا كانت الإدارة الأفضل ستساعد في تخفيف آثار هذه الإصابات".